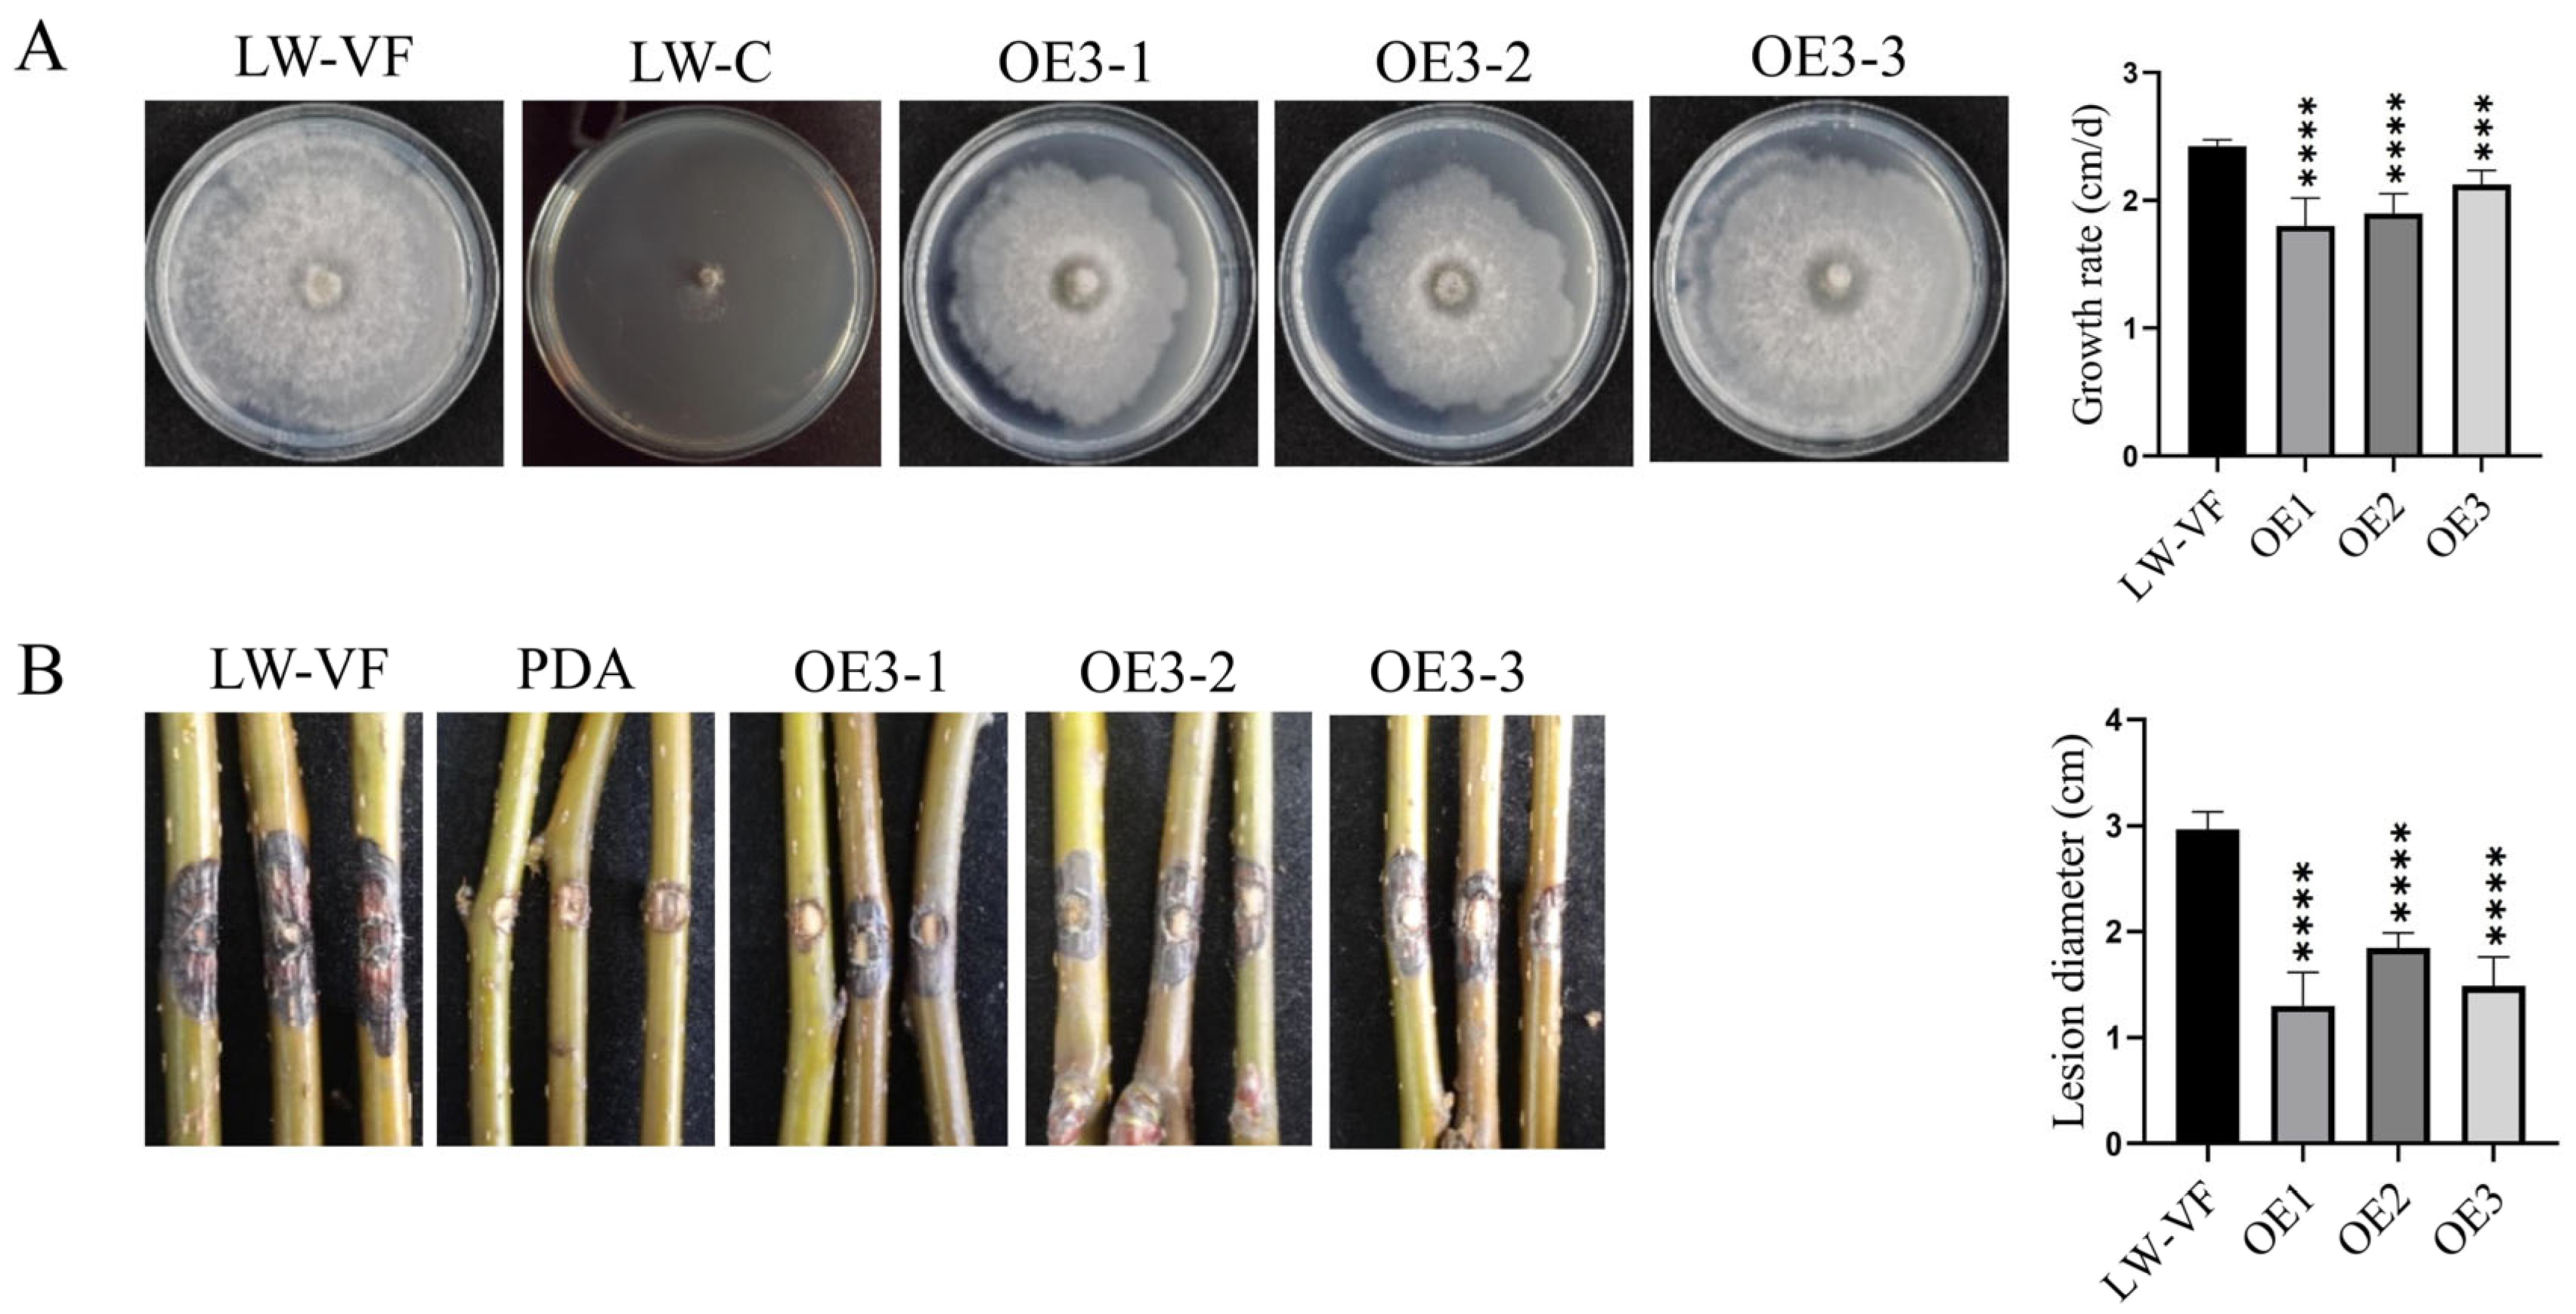
Cells 12 02386 g006

BdCV1-Encoded P3 Silencing Suppressor Identification and Its Roles in Botryosphaeria dothidea, Causing Pear Ring Rot Disease
Abstract
:1. Introduction
2. Materials and Methods
2.1. Botryosphaeria dothidea Strains and Planting Materials
2.2. BdCV1-Encoded Proteins Sequence Amplification and Expressed Vector Construction
2.3. Agrobacterium-Mediated Transient Transformation Test
2.4. The Total Proteins Were Extracted for Western Blot Analysis
2.5. Trypan Blue and DAB Staining
2.6. Protoplast Transformation
2.7. Morphological Observation and Pathogenicity Analysis
2.8. Horizontal Transmission Assay
2.9. Stem-Loop RT-PCR
2.10. RT-qPCR
2.11. cDNA Library Construction and RNA-Seq
2.12. Data Analysis
3. Results
3.1. BdCV1-Encoded P3 Verification as a Potential Fungal RNA Silencing Suppressor in Exotic Plant System
3.1.1. BdCV1-Encoded P3 Could Suppress the Local Silencing of GFP
3.1.2. BdCV1-Encoded P3 Could Suppress dsRNA-Induced RNA Silencing in N. benthamiana
3.1.3. BdCV1-Encoded P3 Affected Cell to Cell Movement of Silencing Signals
3.1.4. BdCV1-Encoded P3 Could Suppress the Systemic Silencing of GFP in N. benthamiana Line 16c
3.2. P3 Induced the Leaf Necrosis Reaction
3.3. The Effects of P3 on Colony Growth and Pathogenicity of B. dothidea Strain
3.4. The Effects of P3 on Gene Expression of B. dothidea Strain by Transcriptome Sequencing
3.5. P3 Is Involved in Host Gene Silencing Pathway
4. Discussion
Supplementary Materials
Author Contributions
Funding
Institutional Review Board Statement
Informed Consent Statement
Data Availability Statement
Acknowledgments
Conflicts of Interest
References
- Zhai, L.; Zhang, M.; Lv, G.; Chen, X.; Jia, N.; Hong, N.; Wang, G. Biological and molecular characterization of four Botryosphaeria species isolated from pear plants showing stem wart and stem canker in China. Plant Dis. 2014, 98, 716–726. [Google Scholar] [CrossRef] [PubMed]
 - Marsberg, A.; Kemler, M.; Jami, F.; Nagel, J.H.; Postma-Smidt, A.; Naidoo, S.; Wingfield, M.J.; Crous, P.W.; Spatafora, J.W.; Hesse, C.N.; et al. Botryosphaeria dothidea: A latent pathogen of global importance to woody plant health. Mol. Plant Pathol. 2017, 18, 477–488. [Google Scholar] [CrossRef] [PubMed]
 - Tang, W.; Ding, Z.; Zhou, Z.; Wang, Y.; Guo, L. Phylogenetic and pathogenic analyses show that the causal agent of apple ring rot in China is Botryosphaeria dothidea. Plant Dis. 2012, 96, 486–496. [Google Scholar] [CrossRef] [PubMed]
 - Ghabrial, S.A.; Caston, J.R.; Jiang, D.; Nibert, M.L.; Suzuki, N. 50-plus years of fungal viruses. Virology 2015, 479–480, 356–368. [Google Scholar] [CrossRef] [PubMed]
 - Liu, S.; Xie, J.; Cheng, J.; Li, B.; Chen, T.; Fu, Y.; Li, G.; Wang, M.; Jin, H.; Wan, H.; et al. Fungal DNA virus infects a mycophagous insect and utilizes it as a transmission vector. Proc. Natl. Acad. Sci. USA 2016, 113, 12803–12808. [Google Scholar] [CrossRef] [PubMed]
 - Hollings, M. Viruses associated with a die-back disease of cultivated mushroom. Nature 1962, 196, 962–965. [Google Scholar] [CrossRef]
 - Wood, H.A.; Bozarth, R.F. Properties of viruslike particles of Penicillium Chrysogenum: One double-stranded RNA molecule per particle. Virology 1972, 47, 604–609. [Google Scholar] [CrossRef]
 - Herring, A.J.; Bevan, E.A. Virus-like particles associated with the double-stranded RNA species found in killer and sensitive strains of the yeast Saccharomyces cerevisiae. J. Gen. Virol. 1974, 22, 387–394. [Google Scholar] [CrossRef]
 - Yu, X.; Li, B.; Fu, Y.; Xie, J.; Cheng, J.; Ghabrial, S.A.; Li, G.; Yi, X.; Jiang, D. Extracellular transmission of a DNA mycovirus and its use as a natural fungicide. Proc. Natl. Acad. Sci. USA 2013, 110, 1452–1457. [Google Scholar] [CrossRef] [PubMed]
 - Yu, X.; Li, B.; Fu, Y.; Jiang, D.; Ghabrial, S.A.; Li, G.; Peng, Y.; Xie, J.; Cheng, J.; Huang, J.; et al. A geminivirus-related DNA mycovirus that confers hypovirulence to a plant pathogenic fungus. Proc. Natl. Acad. Sci. USA 2010, 107, 8387–8392. [Google Scholar] [CrossRef]
 - Nuss, D.L. Hypovirulence: Mycoviruses at the fungal-plant interface. Nat. Rev. Microbiol. 2015, 3, 632–642. [Google Scholar] [CrossRef]
 - Anagnostakis, S.L.; Day, P.R. Hypovirulence Conversion in Endothia-Parasitica. Phytopathology 1979, 69, 1226–1229. [Google Scholar] [CrossRef]
 - Nuss, D.L. Biological control of chestnut blight—An example of virus-mediated attenuation of fungal pathogenesis. Microbiol. Rev. 1992, 56, 561–576. [Google Scholar] [CrossRef] [PubMed]
 - Zhang, H.; Xie, J.; Fu, Y.; Cheng, J.S.; Qu, Z.; Zhao, Z.; Cheng, S.; Chen, T.; Li, B.; Wang, Q.; et al. A 2-kb mycovirus converts a pathogenic fungus into a beneficial endophyte for brassica protection and yield enhancement. Mol. Plant 2020, 13, 1420–1433. [Google Scholar] [CrossRef]
 - Tian, B.; Xie, J.; Fu, Y.; Cheng, J.; Li, B.; Chen, T.; Zhao, Y.; Gao, Z.; Yang, P.; Barbetti, M.J.; et al. A cosmopolitan fungal pathogen of dicots adopts an endophytic lifestyle on cereal crops and protects them from major fungal diseases. ISME J. 2020, 14, 3120–3135. [Google Scholar] [CrossRef] [PubMed]
 - Wang, L.; Jiang, J.; Wang, Y.; Hong, N.; Zhang, F.; Xu, W.; Wang, G. Hypovirulence of the phytopathogenic fungus Botryosphaeria dothidea: Association with a coinfecting chrysovirus and a partitivirus. J. Virol. 2014, 88, 7517–7527. [Google Scholar] [CrossRef]
 - Wang, L.; Luo, H.; Hu, W.; Yang, Y.; Hong, N.; Wang, G.; Wang, A.; Wang, L. De novo transcriptomic assembly and mRNA expression patterns of Botryosphaeria dothidea infection with mycoviruses chrysovirus 1 (BdCV1) and partitivirus 1 (BdPV1). Virol. J. 2018, 15, 126. [Google Scholar] [CrossRef] [PubMed]
 - Luo, H. The Study of Botryosphaeria dothidea LW-Hubei Full-Length Genome Sequence Analysis and the Gene Function of BdDicer2 in B. dothidea in Responsive to Mycovirus. Master’s Thesis, Huazhong Agricultural University, Wuhan, China, 2019. [Google Scholar]
 - Salame, T.M.; Ziv, C.; Hadar, Y.; Yarden, O. RNAi as a potential tool for biotechnological applications in fungi. Appl. Microbiol. Biotechnol. 2011, 89, 501–512. [Google Scholar] [CrossRef]
 - Hutvagner, G.; Simard, M.J. Argonaute proteins: Key players in RNA silencing. Nat. Rev. Mol. Cell Biol. 2008, 9, 22–32. [Google Scholar] [CrossRef]
 - Nakayashiki, H.; Nguyen, Q.B. RNA interference: Roles in fungal biology. Curr. Opin. Microbiol. 2008, 11, 494–502. [Google Scholar] [CrossRef]
 - Ghildiyal, M.; Zamore, P.D. Small silencing RNAs: An expanding universe. Nat. Rev. Genet. 2009, 10, 94–108. [Google Scholar] [CrossRef] [PubMed]
 - Nakahara, K.S.; Masuta, C. Interaction between viral RNA silencing suppressors and host factors in plant immunity. Curr. Opin. Plant Biol. 2014, 20, 88–95. [Google Scholar] [CrossRef] [PubMed]
 - Ye, K.Q.; Malinina, L.; Patel, D.J. Recognition of small interfering RNA by a viral suppressor of RNA silencing. Nature 2003, 426, 874–878. [Google Scholar] [CrossRef] [PubMed]
 - Baulcombe, D.C.; Molnar, A. Crystal structure of p19—A universal suppressor of RNA silencing. Trends Biochem. Sci. 2004, 29, 279–281. [Google Scholar] [CrossRef] [PubMed]
 - Valli, A.A.; Gallo, A.; Rodamilans, B.; Lopez-Moya, J.J.; Garcia, J.A. The HCPro from the Potyviridae family: An enviable multitasking helper component that every virus would like to have. Mol. Plant Pathol. 2018, 19, 744–763. [Google Scholar] [CrossRef]
 - Reed, J.C.; Kasschau, K.D.; Prokhnevsky, A.I.; Gopinath, K.; Pogue, G.P.; Carrington, J.C.; Dolja, V.V. Suppressor of RNA silencing encoded by Beet yellows virus. Virology 2003, 306, 203–209. [Google Scholar] [CrossRef]
 - Baumberger, N.; Tsai, C.H.; Lie, M.; Havecker, E.; Baulcombe, D.C. The Polerovirus silencing suppressor P0 targets ARGONAUTE proteins for degradation. Curr. Biol. 2007, 17, 1609–1614. [Google Scholar] [CrossRef]
 - Brigneti, G.; Voinnet, O.; Li, W.; Ji, L.; Ding, S.; Baulcombe, D.C. Viral pathogenicity determinants are suppressors of transgene silencing in Nicotiana benthamiana. EMBO J. 1998, 17, 6739–6746. [Google Scholar] [CrossRef]
 - Kubota, K.; Tsuda, S.; Tamai, A.; Meshi, T. Tomato mosaic virus replication protein suppresses virus-targeted posttranscriptional gene silencing. J. Virol. 2003, 77, 11016–11026. [Google Scholar] [CrossRef]
 - Voinnet, O.; Lederer, C.; Baulcombe, D.C. A viral movement protein prevents spread of the gene silencing signal in Nicotiana benthamiana. Cell 2000, 103, 157–167. [Google Scholar] [CrossRef]
 - Silhavy, D.; Molnar, A.; Lucioli, A.; Szittya, G.; Hornyik, C.; Tavazza, M.; Burgyan, J. A viral protein suppresses RNA silencing and binds silencing-generated, 21- to 25-nucleotide double-stranded RNAs. EMBO J. 2002, 21, 3070–3080. [Google Scholar] [CrossRef]
 - Suzuki, N.; Maruyama, K.; Moriyama, M.; Nuss, D.L. Hypovirus papain-like protease p29 functions in trans to enhance viral double-stranded RNA accumulation and vertical transmission. J. Virol. 2003, 77, 11697–11707. [Google Scholar] [CrossRef]
 - Aulia, A.; Hyodo, K.; Hisano, S.; Kondo, H.; Hillman, B.I.; Suzuki, N. Identification of an RNA silencing suppressor encoded by a symptomless fungal hypovirus, Cryphonectria Hypovirus 4. Biology 2021, 10, 100. [Google Scholar] [CrossRef]
 - Yu, J.; Park, J.Y.; Heo, J.I.; Kim, K.H. The ORF2 protein of Fusarium graminearum virus 1 suppresses the transcription of FgDICER2 and FgAGO1 to limit host antiviral defences. Mol. Plant Pathol. 2020, 21, 230–243. [Google Scholar] [CrossRef]
 - Wang, S.; Zhang, J.; Nzabanita, C.; Zhang, M.; Nie, J.; Guo, L. Fungal virus, FgHV1-encoded p20 suppresses RNA silencing through single-strand small RNA binding. J. Fungi 2022, 8, 1171. [Google Scholar] [CrossRef]
 - Yaegashi, H.; Yoshikawa, N.; Ito, T.; Kanematsu, S. A mycoreovirus suppresses RNA silencing in the white root rot fungus, Rosellinia necatrix. Virology 2013, 444, 409–416. [Google Scholar] [CrossRef]
 - Guo, L.; Li, J.; Li, B.; Zhang, X.; Zhou, Z.; Li, G.; Wang, Y.; Li, X.; Huang, L.; Sun, G.; et al. Investigations on the occurrence and chemical control of Botryosphaeria canker of apple in China. Plant Protection 2009, 35, 120–123. [Google Scholar]
 - Chen, J. The occurrence and comprehensive control measures of pear ring rot disease. Mod. Agric. Sci. Technol. 2022, 18, 76–79. [Google Scholar]
 - Wang, L. The Study for the Effect of Mycovirus on Biological Characteristics Transcriptom and Small RNAs of Botryosphaeria dothidea Strains. Master’s Thesis, Huazhong Agricultural University, Wuhan, China, 2017. [Google Scholar]
 - Chen, L.; Sun, G.; Wang, H.; Wu, S.; Lin, F.; Liu, H.X. Protoplast preparation and gfp transformation of Botryosphaeria dothidea. Sci. Silvae. Sin. 2014, 50, 131–137. [Google Scholar]
 - Chen, C.; Ridzon, D.A.; Broomer, A.J.; Zhou, Z.; Lee, D.H.; Nguyen, J.T.; Barbisin, M.; Xu, N.; Mahuvakar, V.R.; Andersen, M.R.; et al. Real-time quantification of microRNAs by stem-loop RT-PCR. Nucleic Acids Res. 2005, 33, e179. [Google Scholar] [CrossRef]
 - Livak, K.J.; Schmittgen, T.D. Analysis of relative gene expression data using real-time quantitative PCR and the 2 (-Delta Delta C(T)) Method. Methods 2001, 25, 402–408. [Google Scholar] [CrossRef]
 - Kasschau, K.D.; Carrington, J.C. Long-distance movement and replication maintenance functions correlate with silencing suppression activity of potyviral HC-Pro. Virology 2001, 285, 71–81. [Google Scholar] [CrossRef]
 - Gao, Y. Study on the Regulation Effects of Argonaute and BdCV1-Derived sRNA5636 in Botrosphaeria dothidea with Mycoviruse. Master’s Thesis, Huazhong Agricultural University, Wuhan, China, 2022. [Google Scholar]
 - Myers, J.M.; James, T.Y. Mycoviruses. Curr. Biol. 2022, 32, R150–R155. [Google Scholar] [CrossRef]
 - Hu, W.; Luo, H.; Yang, Y.; Wang, Q.; Hong, N.; Wang, G.; Wang, A.; Wang, L. Comprehensive analysis of full genome sequence and Bd-milRNA/target mRNAs to discover the mechanism of hypovirulence in Botryosphaeria dothidea strains on pear infection with BdCV1 and BdPV1. IMA Fungus 2019, 10, 3. [Google Scholar] [CrossRef]
 - Segers, G.C.; Zhang, X.; Deng, F.; Sun, Q.; Nuss, D.L. Evidence that RNA silencing functions as an antiviral defense mechanism in fungi. Proc. Natl. Acad. Sci. USA 2007, 104, 12902–12906. [Google Scholar] [CrossRef]
 - Segers, G.C.; van Wezel, R.; Zhang, X.; Hong, Y.; Nuss, D.L. Hypovirus papain-like protease p29 suppresses RNA silencing in the natural fungal host and in a heterologous plant system. Eukaryot Cell 2006, 5, 896–904. [Google Scholar] [CrossRef]
 - Shah, U.A.; Kotta-Loizou, I.; Fitt, B.D.L.; Coutts, R.H.A. Mycovirus-Induced Hypervirulence of Leptosphaeria biglobosa enhances systemic acquired resistance to Leptosphaeria maculans in Brassica napus. Mol. Plant Microbe Interact. 2020, 33, 98–107. [Google Scholar] [CrossRef]
 - Campo, S.; Gilbert, K.B.; Carrington, J.C. Small RNA-based antiviral defense in the phytopathogenic fungus Colletotrichum higginsianum. PLoS Pathog. 2016, 12, e1005640. [Google Scholar] [CrossRef]
 - Liu, L.; Xie, J.; Cheng, J.; Fu, Y.; Li, G.; Yi, X.; Jiang, D. Fungal negative-stranded RNA virus that is related to bornaviruses and nyaviruses. Proc. Natl. Acad. Sci. USA 2014, 111, 12205–12210. [Google Scholar] [CrossRef]
 - Feng, H.; Xu, M.; Liu, Y.; Dong, R.; Gao, X.; Huang, L. Dicer-like genes are required for H 2O2 and KCl stress responses, pathogenicity and small RNA generation in Valsa mali. Front. Microbiol. 2017, 8, 1166. [Google Scholar]
 - Feng, H.; Xu, M.; Liu, Y.; Gao, X.; Yin, Z.; Voegele, R.T.; Huang, L. The distinct roles of Argonaute protein 2 in the growth, stress responses and pathogenicity of the apple tree canker pathogen. For. Pathol. 2017, 47, e12354. [Google Scholar] [CrossRef]
 - Zhang, C.; Wu, Z.; Li, Y.; Wu, J. Biogenesis, function, and applications of virus-derived small RNAs in plants. Front. Microbiol. 2015, 6, 1237. [Google Scholar] [CrossRef] [PubMed]
 - Ramesh, S.V.; Yogindran, S.; Gnanasekaran, P.; Chakraborty, S.; Winter, S.; Pappu, H.R. Virus and viroid-derived small RNAs as modulators of host gene expression: Molecular insights into pathogenesis. Front. Microbiol. 2021, 11, 614231. [Google Scholar] [CrossRef] [PubMed]
 - Zhao, C.; Waalwijk, C.; de Wit, P.; van der Lee, T.; Tang, D.Z. EBR1, a Novel Zn2Cys6 Transcription Factor, Affects Virulence and Apical Dominance of the Hyphal Tip in Fusarium graminearum. Mol. Plant Microbe Interact. 2011, 24, 1407–1418. [Google Scholar] [CrossRef] [PubMed]
 - Jonkers, W.; Xayamongkhon, H.; Haas, M.; Olivain, C.; van der Does, H.C.; Broz, K.; Rep, M.; Alabouvette, C.; Steinberg, C.; Kistler, H.C. EBR1 genomic expansion and its role in virulence of Fusarium species. Environ. Microbiol. 2014, 16, 1982–2003. [Google Scholar] [CrossRef]
 - Stefanato, F.L.; Abou-Mansour, E.; Buchala, A.; Kretschmer, M.; Mosbach, A.; Hahn, M.; Bochet, C.G.; Metraux, J.P.; Schoonbeek, H.J. The ABC transporter BcatrB from Botrytis cinerea exports camalexin and is a virulence factor on Arabidopsis thaliana. Plant J. 2009, 58, 499–510. [Google Scholar] [CrossRef]

| Infiltration Treatment | Number of Treated Plants | Number of Systemic Silencing Plants | Suppressing Efficiency (%) | 
|---|---|---|---|
| 35S-GFP + P19 | 25 | 13 | 48% | 
| 35S-GFP + P3 | 25 | 0 | 100% | 
| 35S-GFP + EV | 25 | 20 | 20% | 
| Gene ID | log2FC | Regulation | Function | 
|---|---|---|---|
| GME9697_g | 10.69 | Up | Major facilitator superfamily | 
| GME4842_g | 2.242 | Up | Calcium uniporter protein, mitochondrial | 
| GME7336_g | 2.203 | Up | Zinc finger C2H2-type/integrase DNA-binding protein | 
| GME9654_g | 2.754 | Up | Zinc finger C2H2-type protein | 
| GME10313_g | 1.499 | Up | Phospholipid/glycerol acyltransferase | 
| GME10276_g | 2.094 | Up | Cytochrome P450 | 
| GME3341_g | 9.696 | Up | Putative serine threonine-protein phosphatase pp-z protein | 
| GME2378_g | 9.497 | Up | Putative nitrosoguanidine resistance protein | 
| GME4519_g | 8.885 | Up | Alpha/beta hydrolase fold-1 | 
| GME9641_g | 7.047 | Up | Short-chain dehydrogenase/reductase SD | 
| GME7258_g | 6.767 | Up | Serine hydrolas | 
| GME9987_g | −3.869 | Down | RNA-directed DNA polymerase (reverse transcriptase) | 
| GME1582_g | −5.472 | Down | Putative glycoside hydrolase family 62 protein | 
| GME13543_g | −3.241 | Down | ABC1 family protein | 
| GME3679_g | −7.541 | Down | Putative allantoinase protein | 
| GME8425_g | −11.56 | Down | Alcohol dehydrogenase superfamily zinc-containing | 
| GME596_g | −11.33 | Down | Oxoglutarate/iron-dependent oxygenase | 
| GME1096_g | −9.197 | Down | ABC1 family protein | 
| GME12824_g | −8.550 | Down | Nucleic acid binding OB-fold tRNA/helicase-type | 
| GME1548_g | −8.240 | Down | Ribosomal protein L19 | 
| GME9360_g | −7.578 | Down | Fungus-specific transcription factor domain-containing protein | 
| GME11114_g | −6.576 | Down | FAD-binding domain-containing protein | 
| GME12401_g | −6.076 | Down | Putative C6 zinc finger domain-containing protein | 
| GME13620_g | −4.800 | Down | Glycosyltransferase family 1 protein | 
Disclaimer/Publisher’s Note: The statements, opinions and data contained in all publications are solely those of the individual author(s) and contributor(s) and not of MDPI and/or the editor(s). MDPI and/or the editor(s) disclaim responsibility for any injury to people or property resulting from any ideas, methods, instructions or products referred to in the content.  | 
© 2023 by the authors. Licensee MDPI, Basel, Switzerland. This article is an open access article distributed under the terms and conditions of the Creative Commons Attribution (CC BY) license (https://creativecommons.org/licenses/by/4.0/).
Share and Cite
Li, S.; Zhu, H.; He, Y.; Hong, N.; Wang, G.; Wang, L. BdCV1-Encoded P3 Silencing Suppressor Identification and Its Roles in Botryosphaeria dothidea, Causing Pear Ring Rot Disease. Cells 2023, 12, 2386. https://doi.org/10.3390/cells12192386
Li S, Zhu H, He Y, Hong N, Wang G, Wang L. BdCV1-Encoded P3 Silencing Suppressor Identification and Its Roles in Botryosphaeria dothidea, Causing Pear Ring Rot Disease. Cells. 2023; 12(19):2386. https://doi.org/10.3390/cells12192386
Chicago/Turabian StyleLi, Shanshan, Haodong Zhu, Ying He, Ni Hong, Guoping Wang, and Liping Wang. 2023. "BdCV1-Encoded P3 Silencing Suppressor Identification and Its Roles in Botryosphaeria dothidea, Causing Pear Ring Rot Disease" Cells 12, no. 19: 2386. https://doi.org/10.3390/cells12192386
APA StyleLi, S., Zhu, H., He, Y., Hong, N., Wang, G., & Wang, L. (2023). BdCV1-Encoded P3 Silencing Suppressor Identification and Its Roles in Botryosphaeria dothidea, Causing Pear Ring Rot Disease. Cells, 12(19), 2386. https://doi.org/10.3390/cells12192386
        
